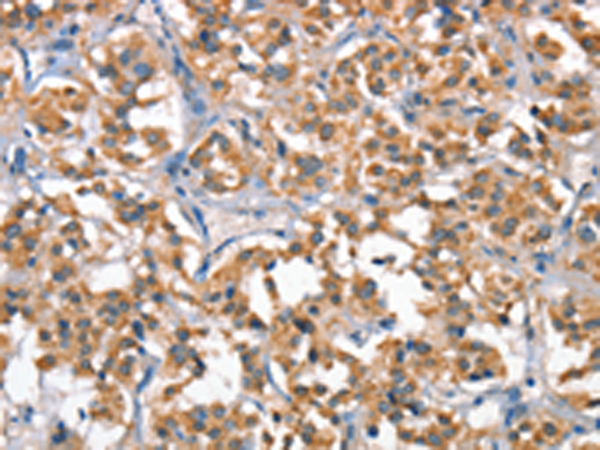

標 記 物: Unconjugate
技術規格
|
Background: |
Hepatocyte growth factor regulates cell growth, cell motility, and morphogenesis by activating a tyrosine kinase signaling cascade after binding to the proto-oncogenic c-Met receptor. Hepatocyte growth factor is secreted by mesenchymal cells and acts as a multi-functional cytokine on cells of mainly epithelial origin. Its ability to stimulate mitogenesis, cell motility, and matrix invasion gives it a central role in angiogenesis, tumorogenesis, and tissue regeneration. It is secreted as a single inactive polypeptide and is cleaved by serine proteases into a 69-kDa alpha-chain and 34-kDa beta-chain. A disulfide bond between the alpha and beta chains produces the active, heterodimeric molecule. |
|
Applications: |
ELISA, IHC |
|
Name of antibody: |
HGF |
|
Immunogen: |
Fusion protein of human HGF |
|
Full name: |
hepatocyte growth factor (hepapoietin A; scatter factor) |
|
Synonyms: |
SF; HGFB; HPTA; F-TCF; DFNB39 |
|
SwissProt: |
P14210 |
|
ELISA Recommended dilution: |
2000-5000 |
|
IHC positive control: |
Human thyroid cancer and Human gastric cancer |
|
IHC Recommend dilution: |
50-200 |

購物車
購物車 幫助
幫助
 021-54845833/15800441009
021-54845833/15800441009
